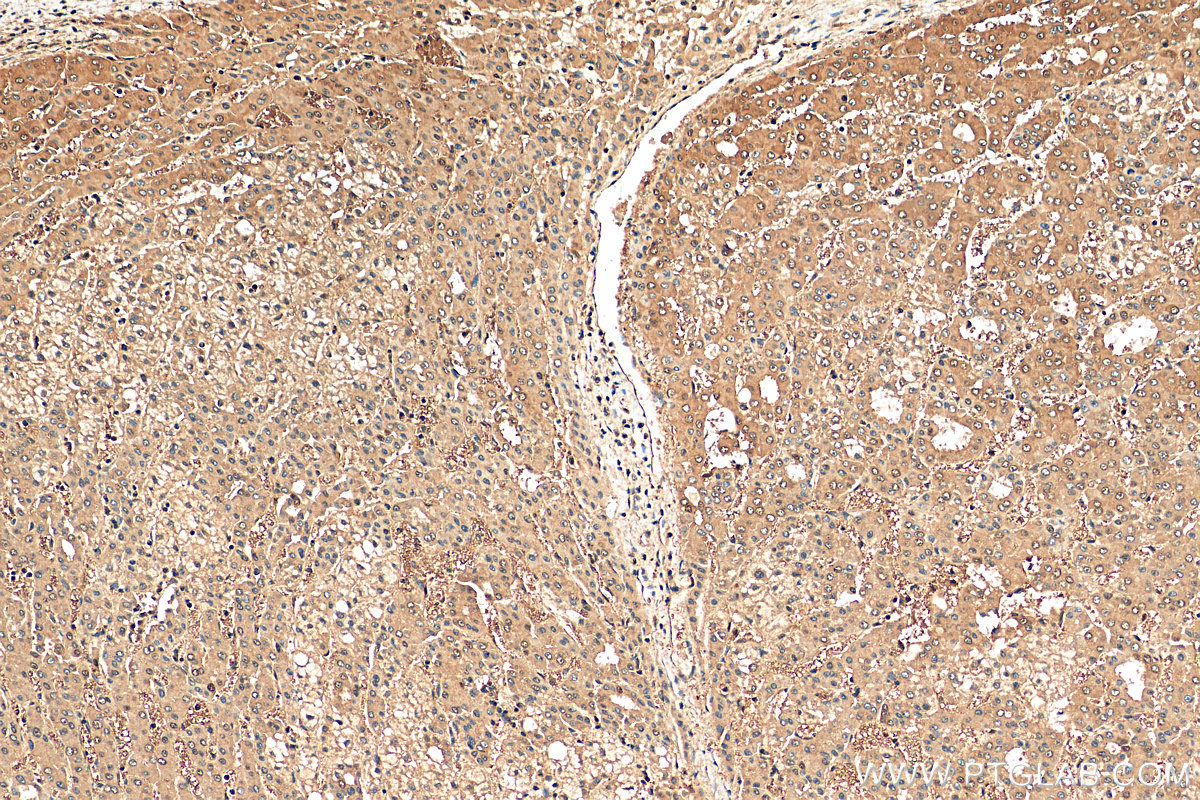

验证数据展示
经过测试的应用
| Positive WB detected in | A431 cells, MDA-MB-453s cells, mouse brain tissue, PC-3 cells, MCF-7 cells, Jurkat cells, SGC-7901 cells, SKOV-3 cells |
| Positive IP detected in | A549 cells |
| Positive IHC detected in | human colon cancer tissue, human breast cancer tissue, human liver cancer tissue Note: suggested antigen retrieval with TE buffer pH 9.0; (*) Alternatively, antigen retrieval may be performed with citrate buffer pH 6.0 |
| Positive IF/ICC detected in | A549 cells |
推荐稀释比
| 应用 | 推荐稀释比 |
|---|---|
| Western Blot (WB) | WB : 1:2000-1:16000 |
| Immunoprecipitation (IP) | IP : 0.5-4.0 ug for 1.0-3.0 mg of total protein lysate |
| Immunohistochemistry (IHC) | IHC : 1:50-1:500 |
| Immunofluorescence (IF)/ICC | IF/ICC : 1:800-1:3200 |
| It is recommended that this reagent should be titrated in each testing system to obtain optimal results. | |
| Sample-dependent, Check data in validation data gallery. | |
产品信息
10515-1-AP targets LASP1 in WB, IHC, IF/ICC, IP, CoIP, ELISA applications and shows reactivity with human, mouse samples.
| 经测试应用 | WB, IHC, IF/ICC, IP, ELISA Application Description |
| 文献引用应用 | WB, IHC, IF, IP, CoIP |
| 经测试反应性 | human, mouse |
| 文献引用反应性 | human, mouse, rat |
| 免疫原 |
CatNo: Ag0800 Product name: Recombinant human LASP1 protein Source: e coli.-derived, PGEX-4T Tag: GST Domain: 125-210 aa of BC012460 Sequence: EFEKSRMGPSGGEGMEPERRDSQDGSSYRRPLEQQQPHHIPTSAPVYQQPQQQPVAQSYGGYKEPAAPVSIQRSAPGGGGKRYRAA 种属同源性预测 |
| 宿主/亚型 | Rabbit / IgG |
| 抗体类别 | Polyclonal |
| 产品类型 | Antibody |
| 全称 | LIM and SH3 protein 1 |
| 别名 | MLN50, LIM and SH3 protein 1, LASP-1 |
| 计算分子量 | 30 kDa |
| 观测分子量 | 38-40 kDa |
| GenBank蛋白编号 | BC012460 |
| 基因名称 | LASP1 |
| Gene ID (NCBI) | 3927 |
| ENSEMBL Gene ID | ENSG00000002834 |
| RRID | AB_2280966 |
| 偶联类型 | Unconjugated |
| 形式 | Liquid |
| 纯化方式 | Antigen affinity purification |
| UNIPROT ID | Q14847 |
| 储存缓冲液 | PBS with 0.02% sodium azide and 50% glycerol, pH 7.3. |
| 储存条件 | Store at -20°C. Stable for one year after shipment. Aliquoting is unnecessary for -20oC storage. |
背景介绍
LASP1(LIM and SH3 protein 1), also known as MLN50, is a 261 amino acid protein that localizes to both the cytoplasm and the cytoskeleton(PMID: 7589475). LASP1 consists of an N-terminal LIM-domain with two zinc finger motifs, followed by two central actin-binding nebulin repeats, flanked by a linker region and a C-terminal SH3 domain (PMID: 17177073, 9848085). LASP-1 interacts with F-Actin and plays an important role in the regulation of Actin-associated cytoskeletal organization. Agonist-dependent changes in LASP1 phosphorylation may regulate Actin-related ion transport activities in epithelial cells (PMID: 15465019,12571245). Overexpression of LASP-1 is associated with breast cancer, and plays a role in tumor transformation and metastasis (PMID: 17956604).
实验方案
| Product Specific Protocols | |
|---|---|
| IF protocol for LASP1 antibody 10515-1-AP | Download protocol |
| IHC protocol for LASP1 antibody 10515-1-AP | Download protocol |
| IP protocol for LASP1 antibody 10515-1-AP | Download protocol |
| WB protocol for LASP1 antibody 10515-1-AP | Download protocol |
| Standard Protocols | |
|---|---|
| Click here to view our Standard Protocols |
发表文章
| Species | Application | Title |
|---|---|---|
Cell Host Microbe Global mapping of Salmonella enterica-host protein-protein interactions during infection. | ||
J Exp Clin Cancer Res RNA-binding protein CCDC137 activates AKT signaling and promotes hepatocellular carcinoma through a novel non-canonical role of DGCR8 in mRNA localization | ||
Oncogene LASP1 interacts with N-WASP to activate the Arp2/3 complex and facilitate colorectal cancer metastasis by increasing tumour budding and worsening the pattern of invasion. | ||
Oncotarget Upregulated long non-coding RNA AFAP1-AS1 expression is associated with progression and poor prognosis of nasopharyngeal carcinoma. | ||
Oncogenesis CCT8 recovers WTp53-suppressed cell cycle evolution and EMT to promote colorectal cancer progression.
| ||
Cancer Lett LASP-1 induces proliferation, metastasis and cell cycle arrest at the G2/M phase in gallbladder cancer by down-regulating S100P via the PI3K/AKT pathway.
|